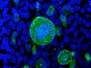

03 May 2012
Building a Virus
Infection with Herpes simplex virus is a relationship that lasts a lifetime. Most sufferers experience cold sores or genital blisters, though viral spread to the brain can be fatal. After an outbreak the virus lies dormant in nerve cells, reawakening periodically to cause infection. Researchers want to discover what form the clandestine virus takes and how it makes new infectious forays. Cryo-electron tomography (left) reveals the blurry shapes of herpes virus components hiding away in a rat brain cell. The computer-generated 3-D reconstruction (right) reveals far greater detail. This team concluded that once the viral DNA wraps up in its protein coat, the resulting football-shaped capsid(light blue) then ‘glues’ to viral proteins (yellow and orange) that help it stick to nerve cells. Finally, the assembled virus hitches a lift to the neighbouring nerve cells in a ‘bubble’ of cell fluid (blue rings).
Written by
- Kay Grünewald
- University of Oxford, UK
- Originally published under Creative Commons (CC-BY 2.0)
- Published in PLos Pathogens
Search The Archive
Submit An Image
Like us on Facebook
Follow on Twitter
Follow on Tumblr
Follow on Instagram
What is BPoD?
BPoD stands for Biomedical Picture of the Day. Managed by the MRC Laboratory of Medical Sciences until Jul 2023, it is now run independently by a dedicated team of scientists and writers. The website aims to engage everyone, young and old, in the wonders of biology, and its influence on medicine. The ever-growing archive of more than 4000 research images documents over a decade of progress. Explore the collection and see what you discover. Images are kindly provided for inclusion on this website through the generosity of scientists across the globe.
BPoD is also available in Catalan at www.bpod.cat with translations by the University of Valencia.